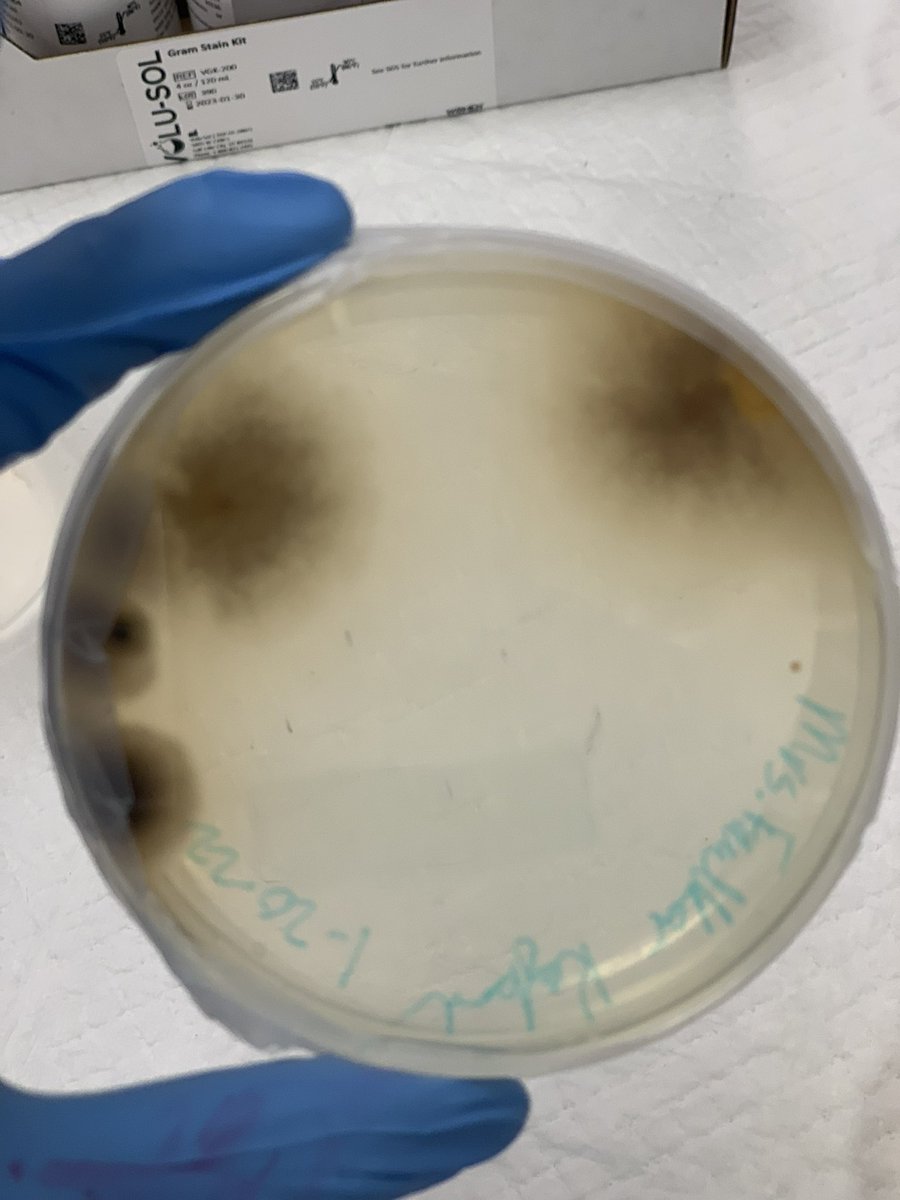
Leander High School tweet media
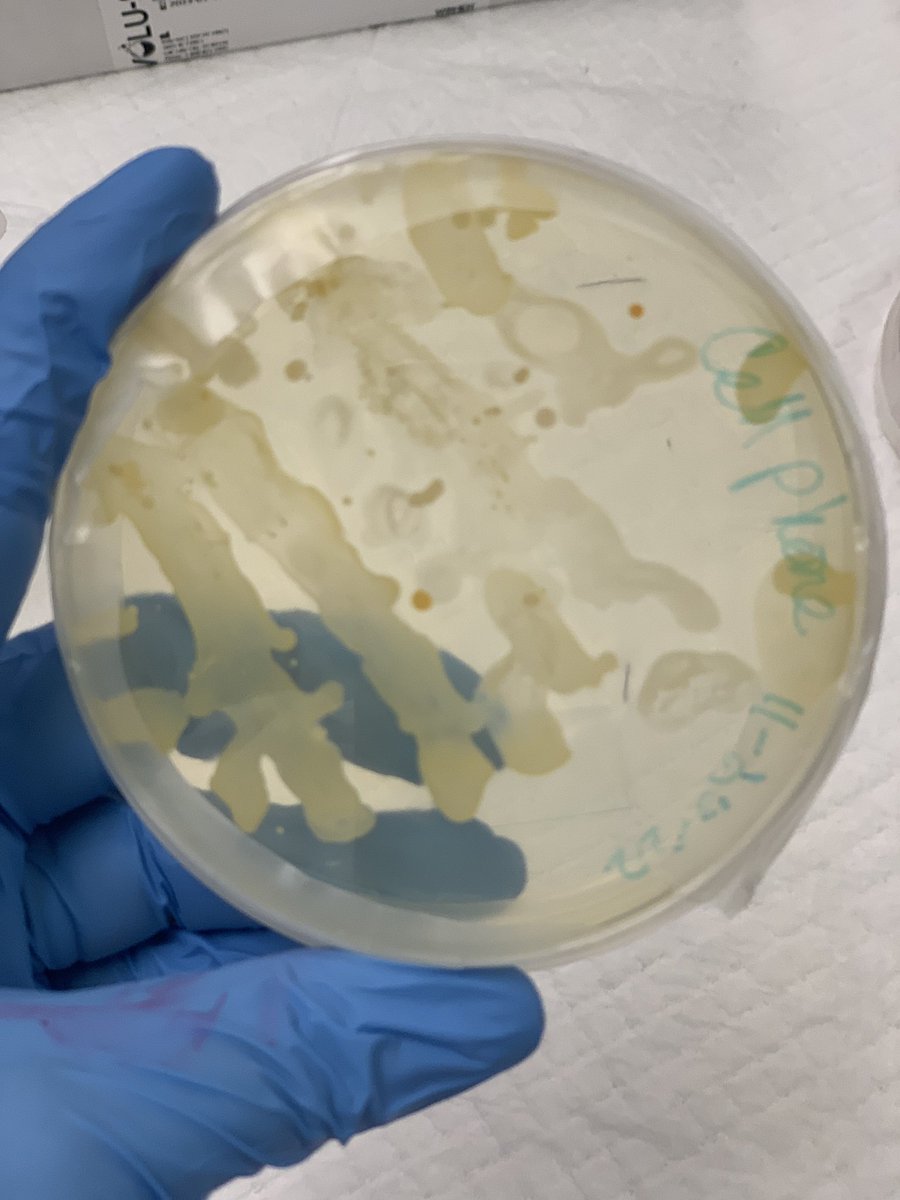
Mrs.V's Classroom tweet media

Mrs.V's Classroom
649 posts

Mrs.V's Classroom
@MrsVeraasClass
Leander High School, Agriculture Science, Vet Med Applications and Practicum, Animal Science, FFA Advisor
Katılım Ağustos 2014
96 Takip Edilen162 Takipçiler

@MrsAgTeacher I have moved my tables closer to the outlets and use some extension cords. They have been a life saver.
English

@MrsVeraasClass How do you secure the cord of your outlet towers to keep kids from tripping on them?? I need these in my classrooms!
English

So much fun to watch students put Flight Zones into practice with this great resource from @OneLessThing.



English

The amazing feeling of finding a @LEEFStrong grant award on your desk after spending a week at major livestock shows with students!!! I can’t wait to use this with students. Thank You LEEF for helping support classrooms!!!!

English

@LeanderHS We aren’t snitches! We can confirm a great cleaning job has occurred to said laptop.
English


@LeanderHS Advanced Animal Science is using @case4learning ASA 2.3.2 Biosecurity:Managing Risk today to learn about how we can work to keep animals healthier in livestock facilities.

English